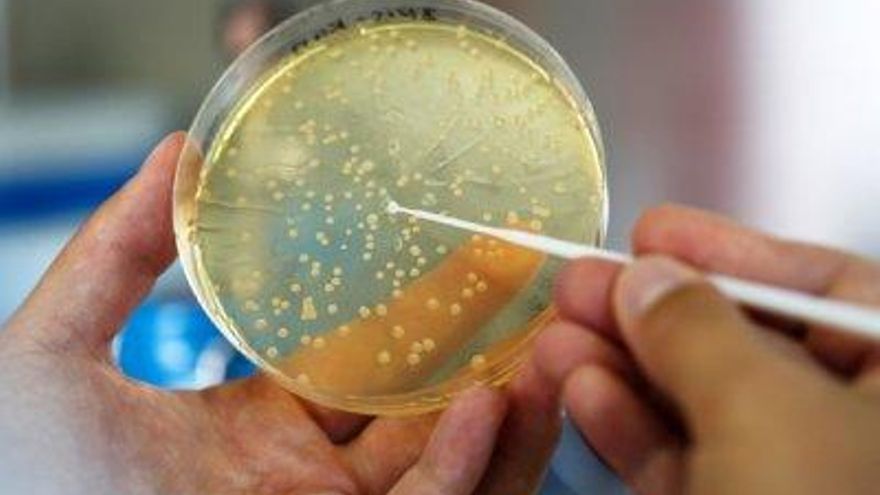

Recursos sobre métodos alternativos a la experimentación con animales

- El Centre for Animal Ethics de la Universitat Pompeu Fabra de Barcelona ha publicado una recopilación de recursos sobre métodos alternativos a la vivisección
Cada 24 de abril se conmemora el Día Internacional del Animal de Laboratorio, una ocasión que debemos aprovechar para seguir alzando la voz en defensa de los no sabemos cuántos millones de animales que nacen, viven y mueren en jaulas de laboratorios y animalarios repartidos por todo el mundo, víctimas no solo de todo tipo de estudios y experimentos sino también de un oscurantismo que nos impide incluso acceder a la información más básica sobre ellos.
Quizás el principal embajador de todos esos animales sea Britches, un pequeño mono nacido en 1985 en un laboratorio de Estados Unidos. Nada más nacer había sido separado de su madre para ser sometido a un estudio sobre los efectos de toda privación sensorial que debía durar tres años. Le cosieron los párpados y le ataron a la cabeza un dispositivo de ultrasonidos con una grabación que oía constantemente. Vivía en una jaula, agarrado a un cilindro metálico sin ninguna atención más allá de la estrictamente necesaria para mantenerlo con vida. Fue rescatado por el Frente de Liberación Animal, curado y rehabilitado, y el mundo empezó a saber lo que ocurre en esos centros de tortura.

Hace unos meses publicamos un artículo sobre las condiciones en las que están los perros beagle con los que practican los alumnos de la Facultad de Veterinaria de la Universidad Complutense de Madrid, y lo peor de aquella investigación fue que suscitó más preguntas de las que pudimos responder. Nos quedó claro que esos perros sirven no solo para que los estudiantes hagan sus prácticas (incluso cuando los animales no están en condiciones físicas y/o emocionales de soportar esas sesiones y permaneciendo toda su vida, hasta trece años en algunos casos, viviendo enjaulados), sino que también son utilizados en estudios de otro tipo. Obtener la información de la propia Universidad es misión imposible, por eso nació Transparencia Animal UCM.
Pero, sobre todo, nos quedamos con muchas preguntas sin resolver. ¿Cuántos más animalarios hay en esa facultad? ¿Y en las demás facultades de Veterinaria de España? ¿Cuántos animales hay en todas ellas? ¿Cuántos animalarios más hay, en hospitales, laboratorios, centros de investigación, etc? No lo sabemos. Lo que sí sabemos es que cada vez son más las personas vinculadas a la ciencia que cuestionan la investigación en animales y apuestan por fomentar métodos alternativos, que se han comprobado incluso más eficaces y que requieren ser desarrollados y avalados, para lo cual es necesario superar los intereses de una industria montada en torno a esos animales.
Por ello, de cara a este 24 de abril, nos parece especialmente interesante hacernos eco de la recopilación de recursos sobre métodos alternativos a la vivisección que ha llevado a cabo el Centre for Animal Ethics de la Universitat Pompeu Fabra de Barcelona. La investigación la han hecho las profesoras Tugce Ataci y Núria Almiron, y la supervisión y edición son de la propia Almiron, Paula Casal, Marta Tafalla, Montserrat Escartín, Catia Faria, Eze Páez, Laura Fernández y Sandra Amigó.
El documento parte de una premisa: cada año, en todo el mundo, millones de animales no humanos son utilizados en experimentos relacionados con la vivisección, es decir, la disección en vivo u otras prácticas invasivas o dañinas para sus cuerpos, con o sin anestesia, incluyendo experimentación psicológica o de trauma en laboratorios, en el ámbito militar, en el educativo u otros entornos. Los experimentos en no humanos pueden durar desde horas a meses y consisten en prácticas que implican todo tipo y grados de dolor físico y psicológico, incluyendo encierro forzado, aislamiento, descargas, adicción a las drogas, inanición, infecciones, quemaduras, disparos, envenenamientos, daños en el tejido cerebral, privación de la vista y manipulación genética, entre otras.
Los dilemas éticos que surgen a partir de estas prácticas son enormes y generan una creciente oposición a la experimentación animal, así como cada vez más interés por las alternativas. Estas alternativas no son nuevas en absoluto, como no lo es el creciente interés por ellas. Hace décadas que organizaciones y científicos/as trabajan en nuevos diseños de medicamentos y métodos de investigación experimental que promueven métodos alternativos más humanos. En la Unión Europea, la legislación exige que los gobiernos nacionales contribuyan económicamente al desarrollo y validación de métodos de investigación sin animales, y el objetivo final de esa regulación es eliminar progresivamente todos los tipos de experimentación animal (Directiva de la Unión Europea 2010/63/UE).

El reemplazo de la vivisección con alternativas compasivas que no incluyan animales es una necesidad urgente e ineludible en el progreso hacia una sociedad más ética. Por eso, el informe recoge algunos de los recursos informativos más relevantes sobre métodos alternativos para facilitar el acceso a los mismos a periodistas, autoridades políticas y el público en general.
El complejo industrial de la vivisección es un gran negocio. El término designa diferentes tipos de organizaciones y empresas cuyos recursos de financiación dependen de, o están relacionados con el uso de animales no humanos para investigación. Esto incluye: empresas públicas o privadas que llevan a cabo directamente o por encargo prácticas de experimentación animal (sobre todo empresas farmacéuticas, pero también químicas, cosméticas y compañías de tabaco, así como gobiernos; instituciones académicas (universidades, laboratorios de invetigación, colegios médicos); y proveedores de animales para investigación y de servicios relacionados con la experimentación animal tales como órganos, instrumentos y formación.
Como en el caso de cualquier otra industria, la de vivisección invierte enormes cantidades de dinero para proteger sus negocios, incluyendo el marketing y las relaciones públicas. No es sorprendente, por tanto, que esta industria se haya convertido en el principal recurso para los medios de comunicación, autoridades políticas y público en general. Sin embargo, hoy en día existe una gran cantidad de información independiente y fiable sobre alternativas a la vivisección. Esta información incluye una amplia variedad de los más recientes métodos con beneficios demostrados de investigación sin animales.
El informe reúne algunos de los recursos más importantes sobre alternativas a la experimentación animal publicados hasta la fecha en todo el mundo. Pueden ser de ayuda para conocer los hechos reales, recopilar información precisa, contactar con autoridades independientes y expertos/as, aprender sobre la validación de alternativas y procedimientos, acceder a oportunidades de financiación, identificar las mejores bases de datos y descubrir bibliografía adicional sobre el tema.
Las listas de recursos proporcionadas para estos fines incluyen: autoridades que validan métodos alternativos; centros de investigación y consorcios involucrados en métodos alternativos: organizaciones que financian investigación sobre métodos alternativos; organizaciones de derechos animales centradas en métodos alternativos; bases de datos; revistas académicas que informan sobre esos métodos, y bibliografía recomendada.
Como hace ese informe, animamos a quien necesite información sobre experimentación animal a que utilice los recursos recomendados en este informe para aprender sobre el creciente número de alternativas y sus beneficios tanto para los humanos como para los no humanos.
1. Autoridades que validan métodos alternativos a la experimentación animal
UE
European Union Reference Laboratory for Alternatives to Animal Testing (Former European Centre for the Validation of Alternative Methods) (EURL-ECVAM)
La implicación de la Comisión Europea en actividades destinadas a validar aproximaciones alternativas a la experimentación animal empezó en 1991 con la creación del ECVAM (European Centre for the Validation of Alternative Methods), presentado por el Joint Research Centre. Desde 2011, las tareas del ECVAM fueron asignadas al EURL-ECVAM. Los laboratorios de investigación pueden presentar los métodos alternativos que hayan desarrollado al EURL-ECVAM para que los valide. El EURL-ECVAM también apoya a los/as investigadores/as en el desarrollo y difusión de sus métodos alternativos para su uso amplio en la industria y aceptación por parte de las autoridades.
European Union Network of Laboratories for the Validation of Alternative Methods (EU-NETVAL)
La EU-NETVAL fue creada por el European Union Reference Laboratory for alternatives to animal testing y el European Centre for the Validation of Alternative Methods (EURL-ECVAM) siguiendo lo requerido por la Directiva 2010/63/EU. Su objetivo es brindar apoyo a los estudios de validación del EURL-ECVAM para evaluar métodos alternativos que puedan usarse para reducir, refinar y remplazar la experimentación animal con fines científicos.
EE.UU.
Interagency Coordinating Committee on the Validation of Alternative Methods (ICCVAM)
El ICCVAM fue fundado en 1997 por el US National Institute of Environmental Health Sciences (NIEHS) con el objetivo de evaluar la validez científica de nuevos métodos alternativos a la experimentación animal y aportar recomendaciones sobre su relevancia, beneficios y utilidad para las agencias federales.
Alemania
Center for Documentation and Evaluation of Alternative Methods to Animal Experiments (ZEBET)
ZEBET se creó en 1989 con el objetivo de limitar el uso de animales para finalidad científica al mínimo necesario y para desarrollar alternativas a los experimentos con animales. Desarrolla, evalúa y valida métodos alternativos y promueve su reconocimiento e implementación en leyes y directivas.
Japón
Japanese Center for the Validation of Alternative Methods (JaCVAM)
La política y misión de JaCVAM es promover las 3Rs (Remplazamiento, Reducción y Refinamiento) en experimentos con animales para la evaluación de sustancias químicas en Japón y establecer guías para nuevos métodos alternativos experimentales a través de la colaboración internacional.
ReinoUnido
National Centre for the Replacement, Refinement & Reduction of Animal in Research (NC3Rs)
NC3s es una organización con sede en Reino Unido fundada con el objetivo de remplazar, refinar y reducir el uso de animales en investigación y experimentación. Financia investigaciones, apoya la colaboración entre universidades y la industria para desarrollar las tecnologías de las 3Rs, y brinda la información más actualizada en avances científicos y tecnológicos para promover la práctica de las 3Rs.
Internacional
International Cooperation on Alternative Test Methods (ICATM)
ICATM fue fundada en 2009 por diferentes agencias internacionales. En 2017, sus miembros eran el Interagency Coordinating Committee on the Validation of Alternative Methods (ICCVAM), el European Union Reference Laboratory for Alternatives to Animal Testing (EURL-ECVAM), el Japanese Center for the Validation of Alternative Methods (JaCVAM), el Health Canada’s Environmental Health Science and Research Bureau (Health Canada) y el Korean Center for the Validation of Alternative Methods (KoCVAM).
2. Centros de investigación y consorcios involucrados en métodos alternativos a la experimentación animal
Este centro es parte del departamento de Animals in Science and Society de la facultad de veterinaria de la universidad de Utrech (Holanda). Promueve el desarrollo, aceptación e implementación de métodos alternativos con las 3Rs.
Center for Alternatives to Animal Testing(CAAT)
El Johns Hopkins Center for Alternatives to Animal Testing fue creado en 1981 en la universidad Johns Hopkins (Estados Unidos). El centro apoya la creación, desarrollo, validación y uso de métodos alternativos a la experimentación animal en investigación, pruebas de seguridad de productos y educación. El centro trabaja de cerca con científicos en la industria, el gobierno y la academia para crear diálogo en torno a las nuevas formas de remplazar la experimentación animal con métodos sin animales y el desarrollo de alternativas.
European Consensus-Platform for Alternatives (ECOPA)
El principal objetivo de ECOPA es promover las 3Rs en el uso de animales en investigación, experimentación, educación y formación en Europa. Entre sus actuales miembros se incluyen: Fincopa (Finnish National Consensus Platform for Alternatives), Francopa (French Platform for the Development of Alternative Methods in Testing), IPAM (Italian Platform on Alternative Methods), Norecopa (Norway’s Consensus-Platform for Replacement, Reduction and Refinement of Animal Experiments), REMA (Red Española para el desarrollo de Métodos Alternativos a la experimentación animal) y SET (German Foundation for the Promotion of Alternate and Complementary Methods to Reduce Animal Testing).
European Partnership for Alternative Approaches to Animal Testing (EPAA)
La EPAA es una colaboración entre la Comisión Europea, las asociaciones empresariales europeas y varias compañías. Se estableció con el propósito de promover conocimiento y recursos para acelerar la validación y aceptación de perspectivas alternativas al uso de animales en experimentación a través del remplazamiento, la reducción y el refinamiento (3Rs).
European Society for Alternatives to Animal Testing (EUSAAT)
EUSAAT promueve la difusión de información sobre métodos libres de crueldad en la experimentación animal, el desarrollo y la validación de procedimientos que apliquen las 3Rs y el uso de métodos alternativos en educación.
Fund for the Replacement of Animals in Medical Experiments (FRAME)
FRAME tiene como objetivo eliminar el uso de animales en cualquier tipo de experimentos médicos o científicos, apostando por el desarrollo de métodos alternativos para el beneficio de humanos, no humanos y el medio ambiente. Gracias a su propio laboratorio y su trabajo de documentación, FRAME investiga y desarrolla nuevos métodos alternativos y colabora con otras organizaciones, la industria y laboratorios.
Human Toxicology Project Consortium (HTPC)
La misión del HTPC es promover un cambio de paradigma global hacía metodologías in vitro con el objetivo de evitar la experimentación animal en la evaluación de riesgos de químicos y medicamentos –metodologías basadas en una comprensión moderna de la biología humana y que brindan resultados más rápidos y precisos.
Japanese Society for Alternatives to Animal Experiments (JSAAE)
La Japanese Society for Alternatives to Animal Experiments es una organización científica que se compromete con actividades de investigación, desarrollo, educación y vigilancia para promover la aceptación internacional de las 3Rs como principios guía para un uso apropiado de los animales en la experimentación científica.
3. Organizaciones que financian investigación sobre métodos alternativos a la experimentación animal
3R Research Foundation Switzerland
La 3R Foundation Switzerland fue fundada en 1987 por el Grupo Parlamentario en Experimentación Animal, Interpharma y la Foundation for Animalfree Research. Su misión es promover métodos de investigación alternativos al uso de animales en experimentación científica a través de becas para proyectos de investigación. También tiene como objetivo implementar y promover los principios de las 3Rs.
Alternatives Research & Development Foundation (ARDF)
La ARDF fue fundada en 1993 con el objetivo de desarrollar alternativas a la experimentación animal en la ciencia. Gracias a sus programas de ayudas, adjudicación de premios y patrocinio de congresos científicos, la ARDF promueve investigación científica que tenga como objetivo remplazar, refinar y reducir el uso de animales. La fundación se enfoca en explorar métodos y modelos sin animales y colabora de cerca con organizaciones y colaboradores de la comunidad científica para ofrecer tecnologías alternativas.
American Fund for Alternatives to Animal Research (AFAAR)
La AFAAR financia un amplio rango de investigación en relación al uso, desarrollo y validación de alternativas. Esto incluye un proyecto conjunto con NEAVS: el Fellowship Grant for Alternatives to Animal Research in Human Health or Sex Differences. El premio apoya las investigadoras postdoctorales en ciencias comprometidas con el uso, desarrollo o validación de alternativas a la investigación con animales en el campo de la salud humana o las diferencias sexuales.
Animal Free Research UK (formerlytheDr.HadwenTrust)
Animal Free Research UK es un organización de investigación científica británica que fue fundada en el año 1970. La organización financia y promueve técnicas sin animales para reemplazar los experimentos con animales. Ofrece subvenciones a científicos/as en universidades, hospitales y organizaciones de investigación promoviendo así la práctica de la investigación sin animales a través de su financiación y publicaciones.
Centre for Documentation and Evaluation of Alternative Methods to Animal Experiments (ZEBETFunding)
El ZEBET trabaja con organismos y organizaciones nacionales e internacionales con el propósito de evaluar científicamente métodos alternativos y promover y difundir su reconocimiento e implementación. El centro proporciona financiación y acoge eventos científicos, incluyendo reuniones de expertos/as con el fin de promover un diálogo más amplio entre universidad, industria, gobiernos y organizaciones de bienestar animal.
La EPAA otorga premios anuales a científicos/as y técnicos/as de laboratorio que deseen y hayan contribuido a la difusión, implementación y desarrollo de métodos alternativos a la experimentación animal.
El Lush Prize reconoce las iniciativas que tienen como objetivo trabajar en el fin o el reemplazo de la experimentación animal, especialmente en el área de la investigación toxicológica. El propósito del premio anual es acelerar la introducción de la experimentación sin animales a través de subvenciones anuales para recompensar a los proyectos e individuos que trabajan en todo el mundo en ámbitos diversos.
Mandom International Research Grantson Alternative to Animal Experiments
Mandom, basado en los principios de bienestar animal y las 3Rs, trabaja para desarrollar la sustitución de los experimentos con animales. Mandom proporciona becas de investigación para investigadores/as que quieran desarrollar métodos alternativos a la experimentación animal en la ciencia.
El Marchig Animal Welfare Trust se fundó en 1989 con el propósito de proteger a los animales y fomentar la investigación y los métodos de prevención de la crueldad animal. La fundación apoya muchos proyectos que incluyen investigación en alternativas a la experimentación animal, la creación de hospitales veterinarios, clínicas, una red de santuarios de animales y apoyo a los grupos de protección de los animales.
Medical Advances Without Animals (MAWA)
MAWA es un centro independiente de investigación médica y fondo fiduciario educativo que tiene como objetivo acelerar el desarrollo de métodos experimentales sin animales en la investigación médica. Financian investigación sobre el reemplazamiento y forman científicos/as en métodos alternativos. El fondo también proporciona subvenciones para equipamiento, becas de investigación y estudio, y patrocinio para científicos/as en Australia.
National Center for the Replacement, Refinement & Reduction of Animals in Research (NC3Rs)
NC3Rs es el principal financiador de investigación en 3Rs en el Reino Unido para proyectos, formación y desarrollo profesional. El centro también financia la comercialización y difusión de las tecnologías de las 3Rs
El Nordic Prize fue fundado en 1996 para premiar el desarrollo de alternativas a la experimentación animal y las contribuciones realizadas por parte de científicos/as y organizaciones para sustituir la experimentación con animales. La Swedish Fund for Research Without Animal Experiments, la Danish Alternativfondety y el Finnish Juliana von Wendts Stiftelse financian este premio anual o semianual.
People for the Ethical Treatment of Animals (PETA)
PETA se fundó en el año 1980 con el objetivo de afirmar y defender los derechos de todos los animales. La organización trabaja de cerca con instituciones educativas, gobiernos e industrias con el objetivo de eliminar la experimentación animal. Proporciona financiación y becas para investigación y validación de pruebas efectivas sin animales.
Swedish Fund for Research Without Animal Experiments
El Swedish Fund for Research without Animal Experiments se fundó en 1964. Ha estado financiando la investigación científica desde el año 1971 con el propósito de promover el desarrollo y la validación de alternativas al uso de animales en la experimentación. Se financia anualmente investigación en métodos alternativos, validación de los métodos y proyectos informativos.
El Swedish Research Council es una agencia pública del Ministerio de Educación e Investigación de Suecia. Financia a investigadores/as para darles la oportunidad de solucionar aspectos concretos de la investigación y promover el desarrollo y difusión de métodos alternativos a la experimentación animal en paralelo con el principio de las 3Rs.
4. Organizaciones de Derechos Animales centradas en métodos alternativos a la experimentación animal
American Anti-Vivisection Society (AAVS)
Desde su fundación en 1883 en los Estados Unidos, la AAVS tiene como objetivo poner fin al uso de animales en experimentos a través de la educación, la defensa y el desarrollo de métodos alternativos en investigación, experimentación y educación. Trabajan con personas físicas, estudiantes, padres y madres, educadores/as, grupos de defensa, industrias, organismos gubernamentales y miembros de la comunidad científica.
El Animal Justice Project es una organización internacional, sin ánimo de lucro dedicada al fin de la experimentación animal y otras formas de especismo. Hacen pública la realidad de la vivisección a través de la defensa, la educación, la divulgación y la investigación.
Cruelty Free International (anteriormente la British Union for the Abolition of Vivisection, fundada en 1898) es un grupo de defensa y protección de los animales que realiza campañas para la abolición de todos los experimentos con animales. Organizan la certificación de productos libres de crueldad, que están marcados con el símbolo de un pequeño conejo saltando.
European Coalition to End Animal Experiments (ECEAE)
La European Coalition to End Animal Experiments (ECEAE) fue fundada en 1990 por organizaciones alrededor de Europa que realizaban campañas para prohibir la experimentación animal con fines cosméticos. Una vez conseguido con éxito este objetivo en 2013, hoy en día dirigen la campaña europea contra todo tipo de experimentación animal. La coalición está formada por un grupo de 20 organizaciones de protección animal de la Unión Europea.
Humane Society International (HSI)
HIS salva animales que han sufrido la experimentación y también proporciona información sobre métodos libres de crueldad y experimentación cosmética y biomédica sin usar animales ni productos animales. Con sus campañas, tratan de concienciar sobre el sufrimiento de los animales en los experimentos de investigación así como de los nuevos métodos más rápidos, seguros y eficientes para remplazar la experimentación animal.
Last Chance for Animals (LCA)
Fundada en 1984 por el actor de Hollywood Chris DeRose, Last Chance For Animals (LCA) tiene sus raíces en combatir y exponer la crueldad inherente a la vivisección.
National Anti-Vivisection Society (NAVS)
La National Anti-Vivisection Society (NAVS) fue fundada en los Estados Unidos en 1929 y trabaja para promocionar soluciones alternativas a los crueles experimentos con animales y reemplazarlos con métodos de investigación modernos e innovadores a través de la colaboración con científicos/as en la academia, el gobierno y la industria. También incentivan a los colegios para integrar la tecnología en las aulas y realizar una experimentación más segura, efectiva y libre de crueldad, preparando así los/as jóvenes investigadores/as para usar técnicas alternativas sin dañar a los animales no humanos.
NewEngland Anti-Vivisection Society (NEAVS)
La NEAVS nace en 1895 en Boston (Estados Unidos) contra el uso de animales en investigación, experimentación y educación. La NEAVS defiende formas modernas de sustituir la experimentación animal a través de la investigación, educación, y cambios políticos y legislativos. Sus publicaciones informan a las personas sobre las formas éticas, compasivas y científicamente superiores de hacer investigación en los campos de la ciencia y la medicina.
People for the Ethical Treatment of Animals (PETA)
PETA se fundó en el año 1980 con el objetivo de afirmar y defender los derechos de todos los animales. La organización trabaja de cerca con instituciones educativas, gobiernos e industrias con el objetivo de eliminar la experimentación animal.
5. Bases de datos sobre métodos alternativos a la experimentación animal
AltBib (ResourcesforAlternativestotheUseofLiveVertebratesinBiomedicalResearchandTesting)
Altweb (AlternativestoAnimalTestingontheWeb)
DB-ALM (EURLECVAMDatabaseServiceonAlternativeMethodstoAnimalExperimentation)
NORECOPA (Noway’sNationalConsensusPlatform)
NORINA (ANorwegianInventoryofAlternatives)
TSAR (TrackingSystemforAlternativetestmethodsReview,ValidationandApprovalintheContextofEURegulationsonChemicals)
UCDavis Center for Animal Alternatives
6. Revistas académicas que informan sobre métodos alternativos a la experimentación animal
AlternativestoAnimalExperimentation (ALTEX)
Editorial: American Society for Cellular and Computational Toxicology
Alternatives to Animal Testing and Experimentation (AATEX) Editorial: Japanese Society for Alternative to Animal Experiments
AlternativestoLaboratoryAnimals (ATLA)
Editorial: Fund for the Replacement of Animals in Medical Experiments
Editorial: Elsevie
Sobre este blog
El caballo de Nietzsche es el espacio en elDiario.es para los derechos animales, permanentemente vulnerados por razón de su especie. Somos la voz de quienes no la tienen y nos comprometemos con su defensa. Porque los animales no humanos no son objetos, sino individuos que sienten, como el caballo al que Nietzsche se abrazó llorando.
Editamos Ruth Toledano, Concha López y Lucía Arana (RRSS).





